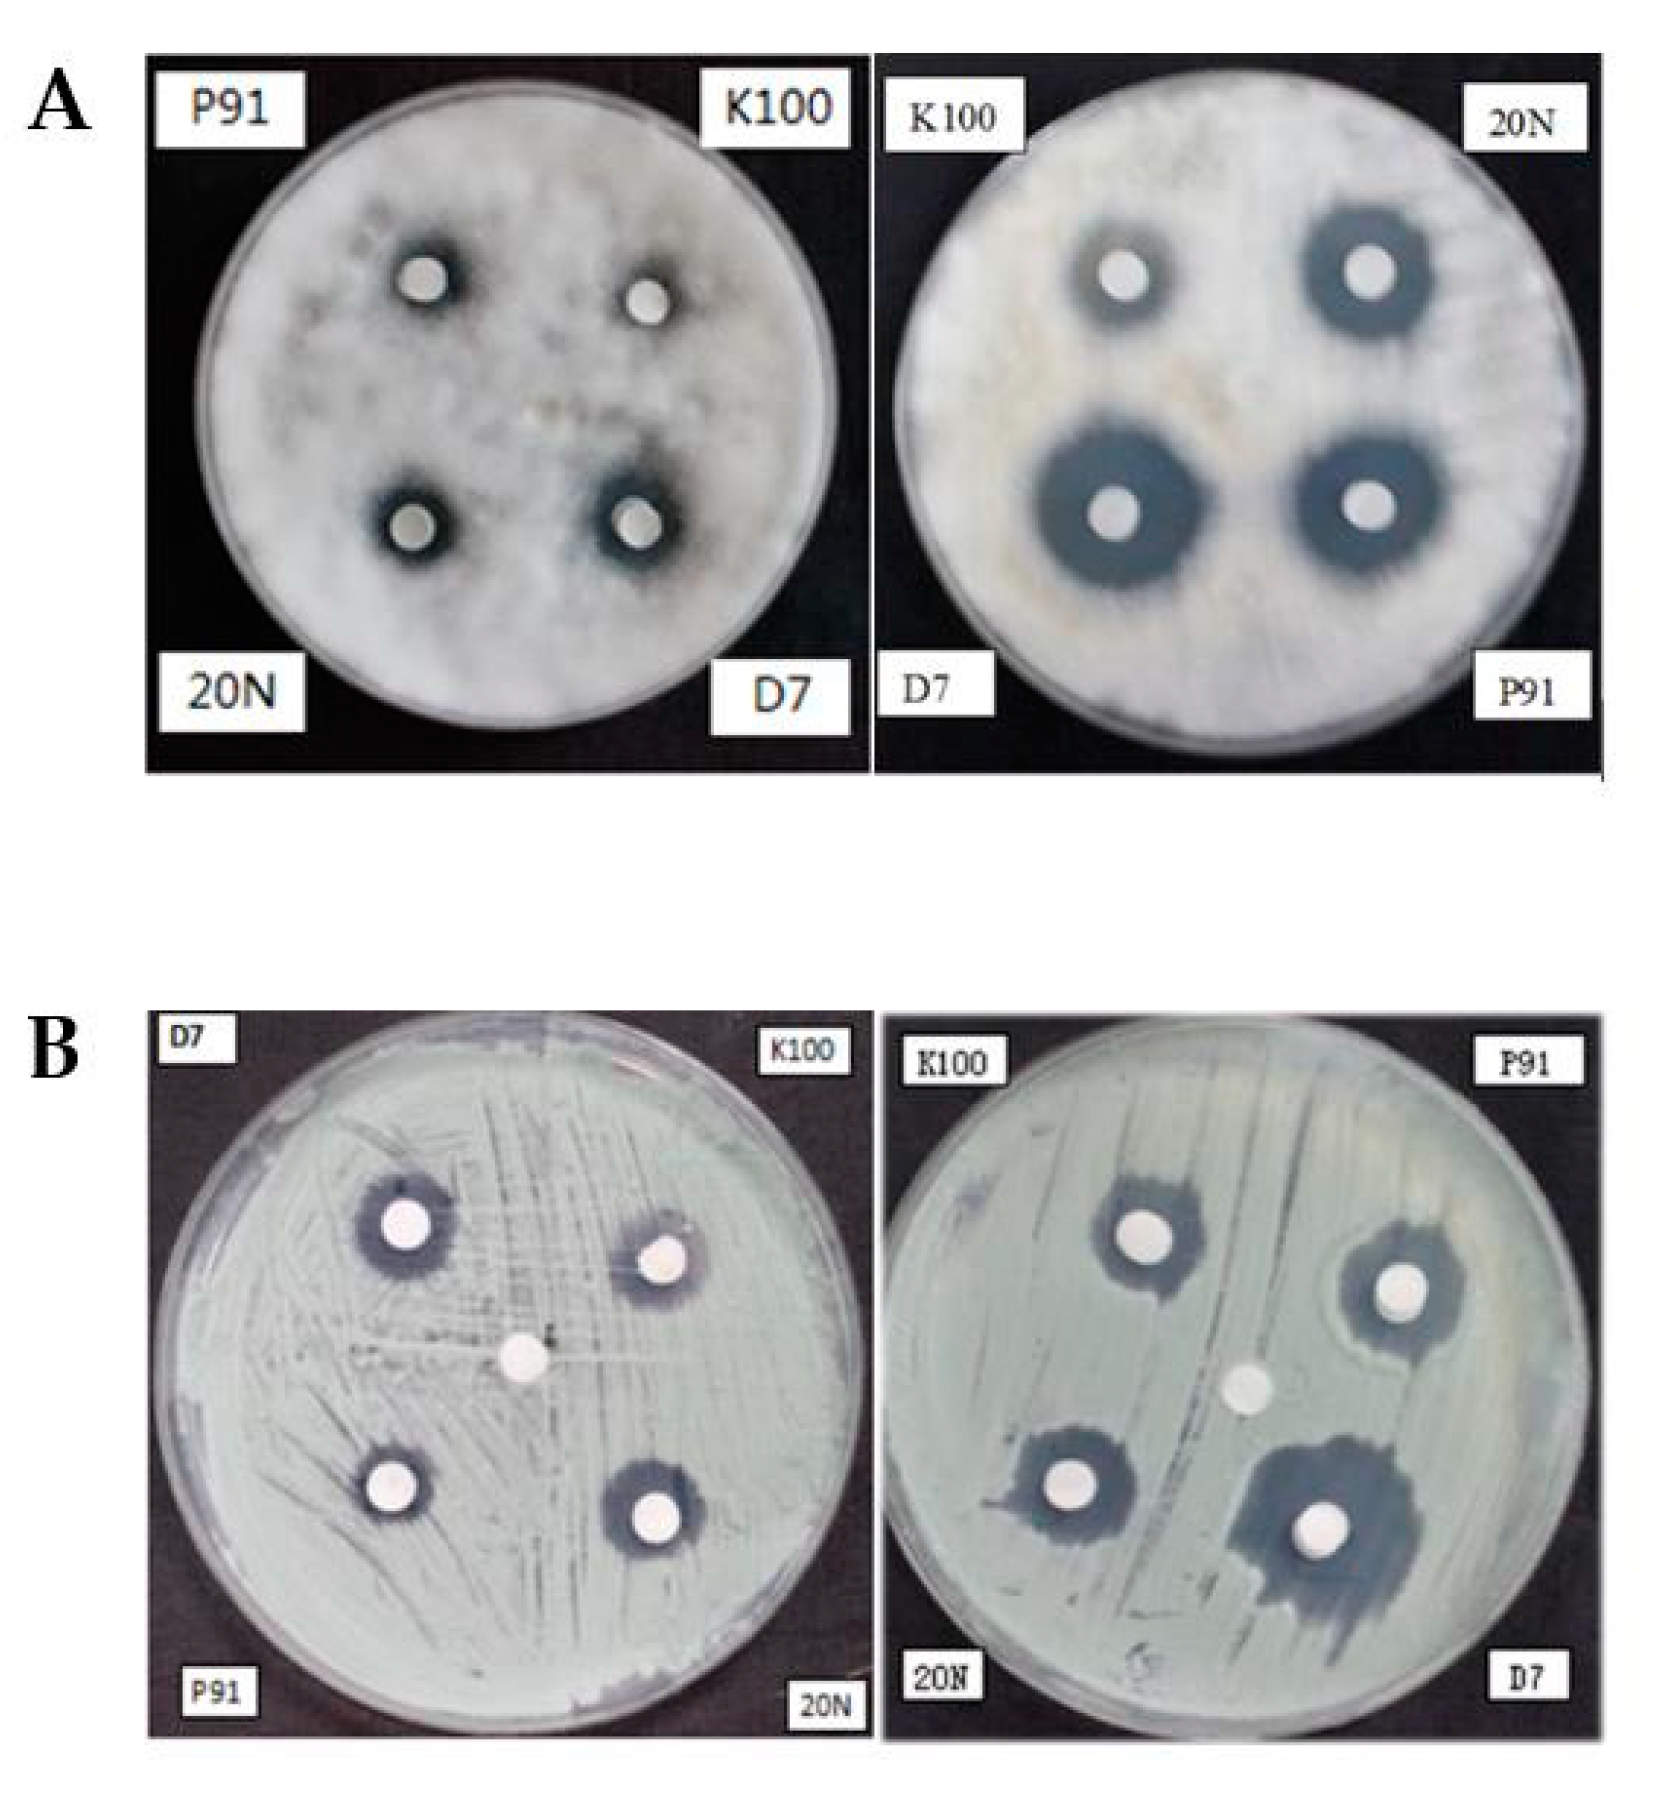

Fungal Community Analysis and Biodeterioration of Waterlogged Wooden Lacquerware from the Nanhai No. 1 Shipwreck
Abstract
1. Introduction
2. Materials and Methods
2.1. Sample Collection
2.2. Microbial Isolation, Cultivation, and Identification
2.3. High-Throughput Sequencing Analysis
2.4. Activity of Carboxymethyl Cellulose (CMCase) Production by Fungi
2.5. Biocide Susceptibility of Fungal Strains
3. Results
3.1. Fungi Communities Analyzed by Classical Cultivation Methods and High-Throughput Sequencing
3.2. Isolation of Dominant Fungi
3.3. Activity of CMCase Production by F. Solani NK-NH1 and P. Chrysogenum NK-NH3
3.4. Efficiency of Biocide Products against Targeted Strains
4. Discussion
4.1. Fungal Communities
4.2. Degradation of Lignocellulose by Fungi
4.3. Biocide Discussion
5. Conclusions
Supplementary Materials
Author Contributions
Funding
Acknowledgments
Conflicts of Interest
References
- You, C.; Han, Y.; Wei, Q. Brief Analysis on the Developmental and Creative Approach of Large-Scale Lacquerware Crafts with Ethnic Characteristics. Art Des. Rev. 2019, 7, 115–123. [Google Scholar] [CrossRef]
- Fang, B.; Wu, S. History, status and future of the conservation and restoration of waterlogged bamboo, wood and lacquer. Sci. Conserv. Archaeol. 2008, 20, 122–130. [Google Scholar]
- Blanchette, R.A. A review of microbial deterioration found in archaeological wood from different environments. Int. Biodeterior. Biodegrad. 2000, 46, 189–204. [Google Scholar] [CrossRef]
- Carpetti, C.; Macchioni, N.; Pizzo, B.; Galotta, G.; Giachi, G.; Giampaola, D. The characterization of waterlogged archaeological wood: The three roman ships found in Naples (Italy). Archaeometry 2008, 50, 855–876. [Google Scholar]
- Gjelstrup Björdal, C. Microbial degradation of waterlogged archaeological wood. J. Cult. Herit. 2012, 13, S118–S122. [Google Scholar] [CrossRef]
- Bucher, V.V.C.; Pointing, S.B.; Hyde, K.D.; Reddy, C.A. Production of Wood Decay Enzymes, Loss of Mass, and Lignin Solubilization in Wood by Diverse Tropical Freshwater Fungi. Microb. Ecol. 2004, 48, 331–337. [Google Scholar] [CrossRef]
- Pournou, A.; Bogomolova, E. Fungal colonization on excavated prehistoric wood: Implications for in-situ display. Int. Biodeterior. Biodegrad. 2009, 63, 371–378. [Google Scholar] [CrossRef]
- Sterflinger, K.; Pinzari, F. The revenge of time: Fungal deterioration of cultural heritage with particular reference to books, paper and parchment. Environ. Microbiol. 2012, 14, 559–566. [Google Scholar] [CrossRef]
- Saarela, M.; Alakomi, H.L.; Suihko, M.L.; Maunuksela, L.; Raaska, L.; Mattila-Sandholm, T. Heterotrophic microorganisms in air and biofilm samples from Roman catacombs, with special emphasis on actinobacteria and fungi. Int. Biodeterior. Biodegrad. 2004, 54, 27–37. [Google Scholar] [CrossRef]
- Xiao, L.; Tang, H.; Yang, T. A preliminary study on microbial degradations during water conservation of unearthed bamboo cases. World Antiq. 2014, 3, 77–80. [Google Scholar]
- Du, J.; Chen, Y.; Liu, J. Preliminary analysis of waterlogged lacquerware from the Nanhai NO.1 shipwreck and take the example of round red lacquer plate. Chin. Cult. Herit. 2019, 05, 46–51. [Google Scholar]
- Polo, A.; Cappitelli, F.; Villa, F.; Pinzari, F. Biological invasion in the indoor environment: The spread of Eurotium halophilicum on library materials. Int. Biodeterior. Biodegrad. 2017, 118, 34–44. [Google Scholar] [CrossRef]
- Liu, Z.; Fu, T.; Hu, C.; Shen, D.; Macchioni, N.; Sozzi, L.; Chen, Y.; Liu, J.; Tian, X.; Ge, Q. Microbial community analysis and biodeterioration of waterlogged archaeological wood from the Nanhai No. 1 shipwreck during storage. Sci. Rep. 2018, 8, 7170. [Google Scholar] [CrossRef] [PubMed]
- Möller, E.M.; Bahnweg, G.; Sandermann, H.; Geiger, H.H. A simple and efficient protocol for isolation of high molecular weight DNA from filamentous fungi, fruit bodies, and infected plant tissues. Nucleic Acids Res. 1992, 20, 6115–6116. [Google Scholar] [CrossRef]
- Liu, Z.; Zhang, Y.; Zhang, F.; Hu, C.; Liu, G.; Pan, J. Microbial Community Analyses of the Deteriorated Storeroom Objects in the Tianjin Museum Using Culture-Independent and Culture-Dependent Approaches. Front. Microbiol. 2018, 9, 802. [Google Scholar] [CrossRef]
- White, T.J.; Bruns, T.; Lee, S.; Taylor, J. Amplification and direct sequencing of fungal ribosomal RNA genes for phylogenetics. In PCR Protocols; Innis, M.A., Gelfand, D.H., Sninsky, J.J., White, T.J., Eds.; Academic Press: San Diego, CA, USA, 1990; pp. 315–322. [Google Scholar]
- Sterflinger, K.; Voitl, C.; Lopandic, K.; Piñar, G.; Tafer, H. Big Sound and Extreme Fungi—Xerophilic, Halotolerant Aspergilli and Penicillia with Low Optimal Temperature as Invaders of Historic Pipe Organs. Life 2018, 8, 22. [Google Scholar] [CrossRef]
- BLAST: Basic Local Alignment Search Tool. Available online: https://blast.ncbi.nlm.nih.gov/Blast.cgi (accessed on 20 May 2020).
- Tuncer, M.; Kuru, A.; Sahin, N.; Isikli, M.; Isik, K. Production and partial characterization of extracellular peroxidase produced by Streptomyces sp F6616 isolated in Turkey. Ann. Microbiol. 2009, 59, 323–334. [Google Scholar] [CrossRef]
- Dupont, J.; Jacquet, C.; Dennetière, B.; Lacoste, S.; Bousta, F.; Orial, G.; Cruaud, C.; Couloux, A.; Roquebert, M.F. Invasion of the French paleolithic painted cave of Lascaux by members of the Fusarium solani species complex. Mycologia 2007, 99, 526–533. [Google Scholar] [CrossRef]
- Martin-Sanchez, P.M.; Nováková, A.; Bastian, F.; Alabouvette, C.; Saiz-Jimenez, C. Use of biocides for the control of fungal outbreaks in subterranean environments: The case of the Lascaux Cave in France. Environ. Sci. Technol. 2012, 46, 3762–3770. [Google Scholar] [CrossRef]
- Lavin, P.; Saravia, S.G.D.; Guiamet, P. Scopulariopsis sp. and Fusarium sp. in the Documentary Heritage: Evaluation of Their Biodeterioration Ability and Antifungal Effect of Two Essential Oils. Microb. Ecol. 2015, 71, 1–6. [Google Scholar] [CrossRef]
- Zhang, N.; O’Donnell, K.; Sutton, D.A.; Nalim, F.A.; Summerbell, R.C.; Padhye, A.A.; Geiser, D.M. Members of the Fusarium solani Species Complex That Cause Infections in Both Humans and Plants Are Common in the Environment. J. Clin. Microbiol. 2006, 44, 2186–2190. [Google Scholar] [CrossRef] [PubMed]
- Samson, R.A.; Hoekstra, E.S.; Frisvad, J.C. Introduction to Food- and Airborne Fungi; Centraalbureau Voor Schimmelcultures: Utrecht, The Netherlands, 2004. [Google Scholar]
- Travadon, R.; Lawrence, D.P.; Rooney-Latham, S.; Gubler, W.D.; Wilcox, W.F.; Rolshausen, P.E.; Baumgartner, K. Cadophora species associated with wood-decay of grapevine in North America. Fungal Biol. 2015, 119, 53–66. [Google Scholar] [CrossRef] [PubMed]
- Di Marco, S.; Calzarano, F.; Osti, F.; Mazzullo, A. Pathogenicity of fungi associated with a decay of kiwifruit. Australas. Plant Pathol. 2004, 33, 337–342. [Google Scholar] [CrossRef]
- Arenz, B.E.; Held, B.W.; Jurgens, J.A.; Farrell, R.L.; Blanchette, R.A. Fungal diversity in soils and historic wood from the Ross Sea Region of Antarctica. Soil Biol. Biochem. 2006, 38, 3057–3064. [Google Scholar] [CrossRef]
- Blanchette, R.A.; Held, B.W.; Jurgens, J.A.; McNew, D.L.; Harrington, T.C.; Duncan, S.M.; Farrell, R.L. Wood-Destroying Soft Rot Fungi in the Historic Expedition Huts of Antarctica. Appl. Environ. Microbiol. 2004, 70, 1328–1335. [Google Scholar] [CrossRef] [PubMed]
- De Filpo, G.; Palermo, A.M.; Munno, R.; Molinaro, L.; Formoso, P.; Nicoletta, F.P. Gellan gum/titanium dioxide nanoparticle hybrid hydrogels for the cleaning and disinfection of parchment. Int. Biodeterior. Biodegrad. 2015, 103, 51–58. [Google Scholar] [CrossRef]
- Anaya, M.; Borrego, S.F.; Gámez, E.; Castro, M.; Molina, A.; Valdés, O. Viable fungi in the air of indoor environments of the National Archive of the Republic of Cuba. Aerobiologia 2016, 32, 513–527. [Google Scholar] [CrossRef]
- Sánchez, C. Lignocellulosic residues: Biodegradation and bioconversion by fungi. Biotechnol. Adv. 2009, 27, 185–194. [Google Scholar] [CrossRef]
- Gao, F.; Yue, H.D.; Qin, X.M.; Lei, Z.H.; Wang, M.L. Research advances on cell wall degrading enzymes produced by pathogenic Fusarium causing plant diseases. Jiangsu J. Agric. Sci. 2018, 34, 955–960. [Google Scholar]
- Chen, J. Modern Plant Pathology Research Methods; China Agriculture Press: Beijing, China, 2005. [Google Scholar]
- Shen, Y.; Hu, T.J.; Zeng, G.M.; Huang, D.L.; Yin, L.; Liu, Y.; Wu, J.J.; Liu, H. Biodegradation of Lignocellulose by Penicillium simplicissimum and Characters of Lignocellulolytic Enzymes. Environ. Sci. 2013, 34, 781–788. [Google Scholar]
- Shen, D.W.; Ge, Q.Y.; Yang, M.; Ma, Q.L. Iron sulfide in the conservation of marine archaeological wood. Sci. Conserv. Archaeol. 2013, 25, 84. [Google Scholar]
- Coutinho, M.L.; Miller, A.Z.; Martin-Sanchez, P.M.; Mirão, J.; Gomez-Bolea, A.; Machado-Moreira, B.; Cerqueira-Alves, L.; Jurado, V.; Saiz-Jimenez, C.; Lima, A.; et al. A multiproxy approach to evaluate biocidal treatments on biodeteriorated majolica glazed tiles. Environ. Microbiol. 2016, 18, 4794–4816. [Google Scholar] [CrossRef] [PubMed]
- De los Ríos, A.; Pérez-Ortega, S.; Wierzchos, J.; Ascaso, C. Differential effects of biocide treatments on saxicolous communities: Case study of the Segovia cathedral cloister (Spain). Int. Biodeterior. Biodegrad. 2012, 67, 64–72. [Google Scholar] [CrossRef]
- Mitova, M.M.; Iliev, M.; Nováková, A.; Gorbushina, A.A.; Groudeva, V.I.; Martin-Sanchez, P.M. Diversity and biocide susceptibility of fungal assemblages dwelling in the Art Gallery of Magura Cave, Bulgaria. Int. J. Speleol. 2017, 46, 67–80. [Google Scholar] [CrossRef]
- Polo, A.; Cappitelli, F.; Brusetti, L.; Principi, P.; Villa, F.; Giacomucci, L.; Ranalli, G.; Sorlini, C. Feasibility of Removing Surface Deposits on Stone Using Biological and Chemical Remediation Methods. Microb. Ecol. 2010, 60, 1–14. [Google Scholar] [CrossRef] [PubMed]
- Morton, L.H.G.; Greenway, D.L.A.; Gaylarde, C.C.; Surman, S.B. Consideration of some implications of the resistance of biofilms to biocides. Int. Biodeterior. Biodegrad. 1998, 41, 247–259. [Google Scholar] [CrossRef]
- Sterflinger, K.; Piñar, G. Microbial deterioration of cultural heritage and works of art—Tilting at windmills? Appl. Microbiol. Biotechnol. 2013, 97, 9637–9646. [Google Scholar] [CrossRef]
- Bastian, F.; Alabouvette, C.; Saiz-Jimenez, C. Bacteria and free-living amoeba in the Lascaux Cave. Res. Microbiol. 2009, 160, 38–40. [Google Scholar] [CrossRef]
- Mehta, J.; Patidar, K.; Vyas, N. Development and validation of a precise method for determination of benzalkonium chloride (BKC) preservative, in pharmaceutical formulation of latanoprost eye drops. J. Chem. 2007, 7, 11–20. [Google Scholar] [CrossRef]
- Stupar, M.; Grbić, M.L.; Džamić, A.; Unković, N.; Ristić, M.; Jelikić, A.; Vukojević, J. Antifungal activity of selected essential oils and biocide benzalkonium chloride against the fungi isolated from cultural heritage objects. S. Afr. J. Bot. 2014, 93, 118–124. [Google Scholar] [CrossRef]
- Scheerer, S.; Ortega-Morales, O.; Gaylarde, C. Microbial deterioration of stone monuments—An updated overview. Adv. Appl. Microbiol. 2009, 66, 97–139. [Google Scholar] [PubMed]
- Favero-Longo, S.E.; Brigadeci, F.; Segimiro, A.; Voyron, S.; Cardinali, M.; Girlanda, M.; Piervittori, R. Biocide efficacy and consolidant effect on the mycoflora of historical stuccos in indoor environment. J. Cult. Herit. 2018, 34, 33–42. [Google Scholar] [CrossRef]

| Taxonomy | Closet Strain | Similarity (%) | Accession Number (GenBank Database) |
|---|---|---|---|
| NHI566 | |||
| Isolate 1 | Penicillium chrysogenum | 99% | KF986423 |
| Isolate 2 | Fusarium solani | 99% | KX349467 |
| NHI883 | |||
| Isolate 3 | Penicillium chrysogenum | 99% | KF986423 |
| Isolate 4 | Fusarium solani | 99% | KX349467 |
| Isolate 5 | Colletotrichum dematium | 99% | JN998109 |
© 2020 by the authors. Licensee MDPI, Basel, Switzerland. This article is an open access article distributed under the terms and conditions of the Creative Commons Attribution (CC BY) license (http://creativecommons.org/licenses/by/4.0/).
Share and Cite
Jia, Y.; Yin, L.; Zhang, F.; Wang, M.; Sun, M.; Hu, C.; Liu, Z.; Chen, Y.; Liu, J.; Pan, J. Fungal Community Analysis and Biodeterioration of Waterlogged Wooden Lacquerware from the Nanhai No. 1 Shipwreck. Appl. Sci. 2020, 10, 3797. https://doi.org/10.3390/app10113797
Jia Y, Yin L, Zhang F, Wang M, Sun M, Hu C, Liu Z, Chen Y, Liu J, Pan J. Fungal Community Analysis and Biodeterioration of Waterlogged Wooden Lacquerware from the Nanhai No. 1 Shipwreck. Applied Sciences. 2020; 10(11):3797. https://doi.org/10.3390/app10113797
Chicago/Turabian StyleJia, Yin, Liuyu Yin, Fengyu Zhang, Mei Wang, Mingliang Sun, Cuiting Hu, Zijun Liu, Yue Chen, Jie Liu, and Jiao Pan. 2020. "Fungal Community Analysis and Biodeterioration of Waterlogged Wooden Lacquerware from the Nanhai No. 1 Shipwreck" Applied Sciences 10, no. 11: 3797. https://doi.org/10.3390/app10113797
APA StyleJia, Y., Yin, L., Zhang, F., Wang, M., Sun, M., Hu, C., Liu, Z., Chen, Y., Liu, J., & Pan, J. (2020). Fungal Community Analysis and Biodeterioration of Waterlogged Wooden Lacquerware from the Nanhai No. 1 Shipwreck. Applied Sciences, 10(11), 3797. https://doi.org/10.3390/app10113797
